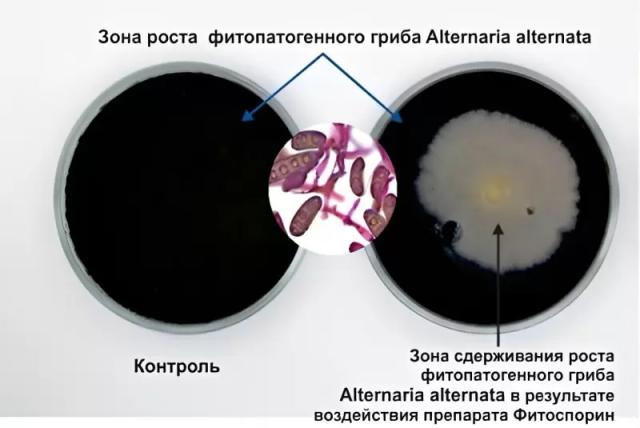

ФИТОСПОРИН АС, Ж – НОВЫЙ УРОВЕНЬ БИОЗАЩИТЫ!
Сегодня чрезвычайно актуальна задача разработки и применения эффективных биологических фунгицидов для борьбы с возбудителями болезней.
Биологические фунгициды создаются на основе различных родов и видов почвенных микроорганизмов, обладающих выраженным антагонизмом против фитопатогенов.
Для создания биологических фунгицидов особенно перспективными являются спорообразующие бактерии рода Bacillus, почвенные грибы рода Trichoderma (триходерма) и ризосферные бактерии рода Pseudomonas, на основе которых разработано множество биологических средств защиты растений от фитопатогенов а также, биопрепаратов, стимулирующих рост и развитие растений.
Состав Фитоспорина АС,Ж
В биофунгициде используются 3 основные группы бактерий - антагонистов фитопатогенов: бациллы, триходерма и лизаты (метаболиты, полисахариды и клеточные стенки) бактерий рода Pseudomonas. Все штаммы относятся к почвенным микроорганизмам, сосуществующими друг с другом в ризосферной зоне корневой системы растений.
Механизмы фунгицидной активности у этих групп микроорганизмов различны и дополняют друг друга в подавлении фитопатогенной микрофлоры.
Первым компонентом препарата являются спорообразующие аэробные бактерии рода Bacillus с известным фунгицидным штаммом B. subtilis 26 Д (иллюстрация 2) (в биопрепарате присутствуют и другие эффективные штаммы бацилл). Эти бактерии выделяет в почву большое количество ферментов, антибиотических веществ и других биологически активных веществ, подавляющих развитие фитопатогенных грибов и бактерий. Наибольшее количество антибиотиков споры сенной палочки выделяют в момент своего прорастания в вегетативную клетку. Следовательно, чем больше в ризосфере спор сенной палочки, тем выше защитный эффект.
Важным фактором воздействия штаммов Bacillus subtilis на растения является его способность к эндофитности, т.е. способность к проникновению через неповрежденные ткани внутрь растения, что вызывает у последних защитные ответы на «инфекцию» (иллюстрация 3). Бактерии запускают у растений клеточный неспецифический иммунитет, основанный на узнавании поверхностных молекул инфекционного агента, что служит первичным сигналом, приводящим в действие сложнейшую сеть процессов индукции и регуляции фитоиммунитета.
Не утрачивают ли бациллы эндофитность после обработки на полях? Этот вопрос волнует многих аграриев.
В лаборатории фитопатологии и селекции микроорганизмов был проведен скрининг образцов растений из хозяйств КФХ «Анохин» и КФХ «Лобов» Ростовской области. Поля, где отбирались образцы, были обработаны в фазу кущения биофунгицидом Фитоспорин-АС,Ж (1 л/га) (иллюстрация 4).
Во всех образцах были обнаружены колонии бактерий Bacillus subtilis 26D, кроме того, в одном образце обнаружено присутствие помимо них аборигенных бактерий этого же рода.
Штамм Bacillus subtilis является бактериальным эндофитом и имеет с растением мутуалистические взаимоотношения. Он колонизируют в растении те же экологические ниши, что и фитопатогенные микроорганизмы, предупреждая тем самым возможность их заражения, т.е. является эффективным агентом биоконтроля фитопатогенов.
Второй компонент. Используемые в препарате Фитоспорин АС,Ж виды грибов рода Trichoderma (иллюстрация 5) (resei, artroviride, longibrachiatum) являются ризосферокомпетентными штаммами. Такие штаммы защищают растения от действия патогенов с помощью прямого подавления фитопатогенных микроорганизмов за счет выработки антибиотических веществ, таких как: триходермин, глиотоксин, виридин, сацуккалин и др, а также гидролитических ферментов, и других биоактивных веществ, подавляющих рост или уничтожающих фитопатогены. Защитный эффект грибов Триходермы также осуществляется за счет индуцирования ими системной и локальной устойчивости растений к действию фитопатогенов. Растущие гифы грибов Триходермы способны проникать в межклетники корневых волосков растений.
Такое проникновение Триходермы не вредит растению, но действует как «вакцина» от возможного проникновения фитопатогена, т.к. приводит к увеличению уровня защитных ферментов растений, в том числе: пероксидаз, хитиназ, β-1,3-глюканаз и фермента липоксигеназного пути гидроксипероксид лиазы. За счет такого повышения системной устойчивости растений под влиянием Триходермы, ее эффект, как биоконтрольного агента, сохраняется дольше.
Третьим компонентом биопрепарата Фитоспорин АС,Ж является лизаты бактерий рода Pseudomonas, содержащий метаболиты бактерий, полисахариды бактериальной слизи и гликополисахариды бактериальных клеток, также обладающий выраженной фунгицидной активностью, а также ростостимулирующим действием, особенно на корневую систему с/х культур.
К механизмам положительного влияния псевдомонад и их метаболитов на растения относятся: 1) прямая или непосредственная стимуляция роста растений за счет синтеза различных метаболитов, полезных для растений, в том числе гормоноподобных веществ; 2) опосредованная стимуляция роста растений за счет вытеснения и подавления развития почвенных фитопатогенов, угнетающих рост растений.
Эффект для растений.
Фитоспорин АС, Ж характеризуется широким спектром действия в отношении фитопатогенных грибов из классов фикомицеты, базидиомицеты и несовершенные грибы: фузариозная и гельминтоспориозная корневые гнили, плесневение семян, мучнистая роса и др.
При применении биофунгицида Фитоспорина АС,Ж в отличии от химических фунгицидов:
- не угнетается жизнедеятельность аборигенной микрофлоры;
- не происходит формирования у фитопатогенов резистентности к биопрепарату, что позволяет проводить обработки неоднократно, до получения положительного результата;
- повышается местная и системная устойчивость растений к биогенным и абиогенным стрессам.
Использование биофунгицида эффективно защищает сельскохозяйственные культуры от патогенов, оказывая помимо фунгицидного и бактерицидного эффекта, также антистрессовое и ростостимулирующее действие.
В.С. Сергеев, зам. директора по науке НВП «БашИнком»

6 комментариев
Может ли кто-то из участников DIRECT.FARM поделиться мнением по данному препарату?